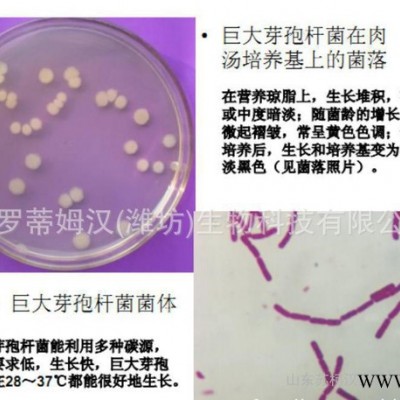

| 主要成分 | 生物菌 |
|---|---|
| 含量≥ | 100(%) |
| 水分 ≤ | 8(%) |
| 适用范围 | 农业 |
| 外观 | 粉末 |
| 生产厂家 | sukahan |
| 新奇创意项目 | 报名 |
| 主要成分:生物菌 | 含量≥:100(%) |
| 水分 ≤:8(%) | 适用范围:农业 |
| 外观:粉末 | 生产厂家:sukahan |
| 新奇创意项目:报名 |
固氮菌益生菌剂
百欧盖恩TM微生物冲施菌肥
产品简介:
百欧盖恩TM微生物冲施肥是一种微生物产品,含有多种高浓度高活性的有益微生物菌群,包括凝结芽孢杆菌、巨大芽孢杆菌、棕色固氮菌、胶质芽孢杆菌、米曲霉、长柄木霉。
百欧盖恩微生物冲施肥中的生物菌群能通过土壤吸收养分,尤其是对钾和存在于磷酸盐(PO43-)中磷的吸收效果突出.并将这些养分转移给植物来弥补根部生长不良的缺陷。这些有益生物菌与植物形成一种共生关系,刺激植物根部的分枝并增大根部吸收面积,起到固氮、解磷、解钾、促进植物根系生长并保护植物不受致病菌侵容的作用。
作用机理:
百欧盖恩TM微生物冲施肥内含的六大生物菌群即凝结芽孢杆菌、巨大芽孢杆菌、棕色固氮菌、胶质芽孢杆菌、米曲霉、长柄木霉能在植物根部内外生长。这些有益生物菌群生长在主体植物的根部,并与主体植物形成共生关系,不仅可以捉进植物根系的生长,为其提供所需的营养成分,同时植物也为有益菌的生长提供了条件。根部长有这些有益生物菌群的植物可以更好的吸收磷,并增强其抗盐、杭旱、保持水分平衡的能力从而促进植物本身的生长发育。蔬莱、果树、大姜、草莓等与有益生物菌群有共生关系的植物在以下方面性能更好:耐土壤高温、调节PH值、抗致病菌侵害以及抗重金属毒性。
有益生物菌群:
百欧盖恩TM微生物冲施肥含有多种高浓度的非致病性有益微生物菌群包括凝结芽孢杆菌、巨大芽孢杆菌、棕色固氮菌、胶质芽孢杆菌、米曲霉、长柄木霉。这些有益生物菌群能与植物形成共生关系,促进植物根系生长,保护植物充分吸收养分的同时,植物也为其提供了养分。
百欧盖恩TM微生物冲施肥中生长良好的生物有益菌群能从土壤中吸收养分并分解土壤中的复和物质生成植物可直接利用的营养元素,尤其是吸收钾和磷【存在于磷酸盐(PO43-)中】,然后将这些养分转移给植物来弥朴根系不发达的不足,从而促进根系的生长并起到固氮、促进植物生长并保护植物不受致病菌侵害的作用。
技术指标:
菌数:3亿CFU/g,包括40%的凝结芽孢杆菌,20%巨大芽孢杆菌,20%棕色固氮菌,10%胶质芽孢杆菌,5%米曲霉和5%的长柄木霉。
产品性状:
外观:深棕色粉末
气味:轻微发酵味
pH: 6.5 -8.0
产品优势:
¨ 化学肥料的有效补充剂。微生物能自然释放氮、磷、钾,因而可减少化学肥料的投入,降低使用化肥的成本;增加作物产量。
¨ 通过刺激根系的生长和营养成分的吸收,从而促进植物生长。
¨ 通过固氮作用和共生作用激活土壤,产生有机质恢复土壤的自然肥力并能改善土壤的结构、纹理和通风,增强土壤的储水能力。
¨ 生物环保(由有机物质分解而成,不含化学有害物质)。
¨ 通过有益微生物的天然抗菌性和杭病性来保护植物免受病菌的侵害、抗早。
¨ 可用作农田或莱地的施用肥。
产品有效期:三年。
使用方法:
将百欧盖恩TM微生物冲施肥二次稀释,随水冲施。
注意事项:
¨ 不可与杀菌剂混合使用。
¨ 初次使用请做对比试验,以验证本品效果。
¨ 本品应放在阴凉干燥处储存,防晒,结块不影响肥效。